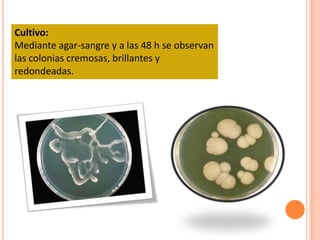
Cultivo:
Mediante agar-sangre y a las 48 h se observan
las colonias cremosas, brillantes y
redondeadas.

La candidiasis oral es una infección frecuente causada por el hongo Candida albicans. Puede presentarse en forma aguda o crónica, con síntomas como manchas blancas en la boca. Se diagnostica clínicamente o mediante exámenes como frotis y cultivo que buscan la presencia del hongo. Los factores de riesgo incluyen uso de antibióticos, xerostomía e inmunosupresión. El tratamiento depende de la gravedad y puede incluir enjuagues bucales o medicamentos antifú